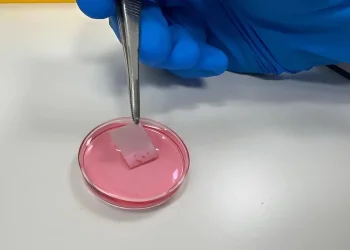
מדע החיים: מהפכה ישראלית בטיפול בכוויות &ndash; שתל עור מהונדס מתאי המטופל
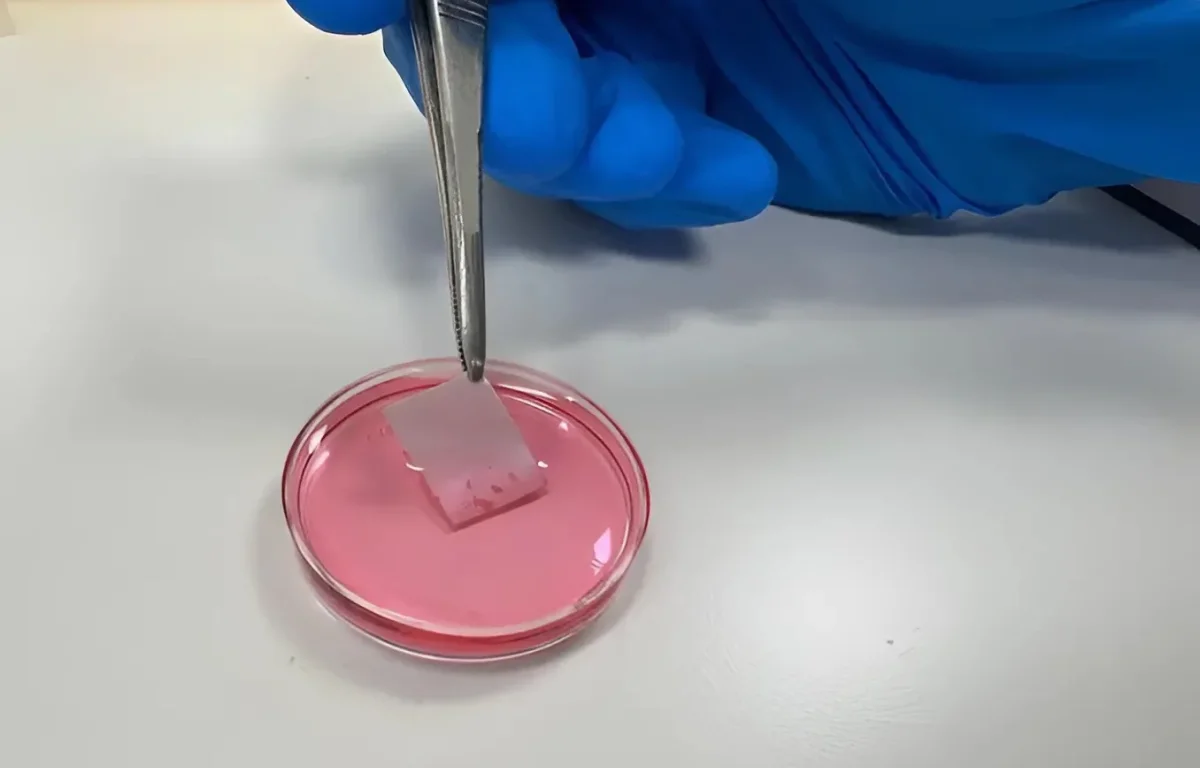
מדע החיים: מהפכה ישראלית בטיפול בכוויות &ndash; שתל עור מהונדס מתאי המטופל

בריאות
בזמן שבו העולם הרפואי כולו מתמודד עם מגבלות הטיפול בכוויות נרחבות - בישראל הושגה לאחרונה התקדמות מדעית מרשימה, שעשויה לשנות את פני התחום. צוות חוקרים מאוניברסיטת תל אביב ובית החולים שיבא פיתחו שתל עור מהונדס, שמבוסס על תאי עור של המטופל עצמו. מדובר בשיטה חדשנית שאינה רק מבטיחה הקלה משמעותית בתהליך הריפוי - אלא משנה את כל הגישה לתיקון רקמות פגועות.
כוויות מדרגה שנייה ושלישית נחשבות לאחת הפגיעות הקשות ביותר מבחינת כאב, סיכון לזיהומים ופגיעה תפקודית. הפתרון השכיח כיום - השתלת עור עצמי - מחייב לקיחת עור בריא מאזורים אחרים בגוף, ולעיתים, כפי שמסבירה פרופ' ליהי אדלר-אברמוביץ מאוניברסיטת תל אביב, "אין די עור תקין לשימוש. אנו יוצרים פצע נוסף כדי לטפל בפצע המקורי".
הפיתוח החדש מבוסס על הנדסת רקמות: חוקרים נוטלים ביופסיה קטנה מעורו של המטופל, ממנה מבודדים תאי גזע. אלה מגודלים בתנאי מעבדה עד ליצירת שכבת עור שלמה. אלא שכאן נכנסת החידוש האמיתי - היכולת ליצור יריעה גמישה ועמידה, שמדמה עור אנושי מלא, הכולל גם שכבות עמוקות יותר כמו פיברובלסטים.
השתל, שכונה "יריעת עור ביולוגית", כולל גם תוספת ייחודית - פפטיד קצר שמחובר לחומר הפולימרי ממנו עשוי השתל. פפטיד זה מדמה חלבונים טבעיים בגוף, וכך מסייע לתאי העור להיקלט ולהתפתח עליו באופן טבעי.
בישראל כבר נעשה שימוש בטכניקות כמו CEA - תרבית אפידרמיס אוטולוגית - אך אלו מבוססות לעיתים על תאים ממקורות חיצוניים (כמו עכברים), מה שמחייב פיקוח קפדני מצד הרשויות. נוסף לכך, שתלים קיימים נוטים להתכווץ באופן משמעותי ולספק רק את שכבת העור העליונה, דבר שמקשה על היישום בחדרי ניתוח.
לעומת זאת, המוצר שפיתחו החוקרים המקומיים מצליח לשלב עמידות, עובי, גמישות והתאמה מושלמת לפרופיל הביולוגי של המטופל - וכל זאת ללא מקור תאי זר.
השתלים החדשים נבדקו בניסויים פרה-קליניים על בעלי חיים, והראו תוצאות מרשימות: שיפור משמעותי במהירות ההחלמה, ירידה בסיכון לזיהומים, וקלות תפעול כירורגית. ד"ר אילת די סגני, מנהלת בנק הרקמות בשיבא, הדגישה כי "השתל יציב, נוח להעברה, ואינו מתקפל בקצוות כמו שתלים עדינים אחרים".
לדברי פרופ' אדלר-אברמוביץ, המהלך נמצא בשלב מתקדם של פיתוח, תחת מסגרת מחקרית משותפת עם צוותים קליניים בשיבא. "אנחנו עומדים בתקן הקליני המחמיר, ועוברים כעת תהליך רגולציה לקראת ניסויים בבני אדם".
מעבר לפתרון עבור פצועי כוויות - הפיתוח עשוי לשמש גם בטיפול בפצעים כרוניים, כיבים סוכרתיים, ומצבים נוספים הדורשים שחזור רקמות עור. "החזון שלנו", מוסיפה פרופ' אדלר-אברמוביץ, "הוא לא רק לטפל בנפגעי טראומה, אלא לשנות את איכות החיים של אלפי חולים שנאלצים כיום להסתפק בטיפולים חלקיים בלבד".
הפרויקט הובל על ידי צוות בינתחומי שכלל את פרופ' אדלר-אברמוביץ והדוקטורנטית דנה כהן-ג'רסי מאוניברסיטת תל אביב, בשיתוף עם ד"ר אילת די סגני, ד"ר מרינה בן-שושן, ד"ר מוטי חרץ, פרופ' יוסי חייק, ד"ר עמית סיט וד"ר עדי ליאאני - כולם בעלי תפקידים מרכזיים במרכז הרפואי שיבא ובאקדמיה.
לחצו כאן לקבלת כל העדכונים, הסיפורים והחיזוקים של ערוץ 2000 בוואטסאפ >>>
מצאתם טעות בכתבה? כתבו לנו